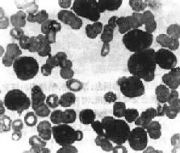

文件列表
来自医学百科
本特殊页面展示所有上传的文件。
| 日期 | 名称 | 缩略图 | 尺寸 | 用户 | 说明 | 版本 |
|---|---|---|---|---|---|---|
| 2014年1月17日 (五) 11:49 | Bkckz.jpg (文件) |  |
26 KB | Admin | 1 | |
| 2014年1月17日 (五) 11:49 | Bkiki.jpg (文件) |  |
34 KB | Admin | 1 | |
| 2014年1月17日 (五) 11:49 | Gkru5jpc.jpg (文件) |  |
27 KB | Admin | 1 | |
| 2014年1月17日 (五) 11:49 | Bkba0.jpg (文件) |  |
31 KB | Admin | 1 | |
| 2014年1月17日 (五) 11:49 | Bkaxy.jpg (文件) |  |
37 KB | Admin | 1 | |
| 2014年1月17日 (五) 11:49 | Gyl7t458.jpg (文件) |  |
46 KB | Admin | 1 | |
| 2014年1月17日 (五) 11:49 | Bk2tu.jpg (文件) |  |
49 KB | Admin | 1 | |
| 2014年1月17日 (五) 11:49 | Gmopw398.jpg (文件) |  |
17 KB | Admin | 1 | |
| 2014年1月17日 (五) 11:49 | Bk5fr.jpg (文件) |  |
86 KB | Admin | 1 | |
| 2014年1月17日 (五) 11:50 | Bkdhc.jpg (文件) |  |
42 KB | Admin | 1 | |
| 2014年1月17日 (五) 11:50 | Gl98mc9z.jpg (文件) |  |
7 KB | Admin | 1 | |
| 2014年1月17日 (五) 11:50 | Bkk9v.jpg (文件) |  |
6 KB | Admin | 1 | |
| 2014年1月17日 (五) 11:50 | Bkku7.jpg (文件) |  |
125 KB | Admin | 1 | |
| 2014年1月17日 (五) 11:50 | Gj6wkv2l.jpg (文件) | |
12 KB | Admin | 1 | |
| 2014年1月17日 (五) 11:50 | Bkp4t.jpg (文件) |  |
221 KB | Admin | 1 | |
| 2014年1月17日 (五) 11:50 | Bkmg9.jpg (文件) |  |
138 KB | Admin | 1 | |
| 2014年1月17日 (五) 11:50 | Bklt7.jpg (文件) |  |
13 KB | Admin | 1 | |
| 2014年1月17日 (五) 11:50 | Bkpf1.jpg (文件) |  |
8 KB | Admin | 1 | |
| 2014年1月17日 (五) 11:51 | Bkqv6.jpg (文件) |  |
8 KB | Admin | 1 | |
| 2014年1月17日 (五) 11:51 | Gzo6q6qw.gif (文件) |  |
12 KB | Admin | 1 | |
| 2014年1月17日 (五) 11:51 | Bkbla.jpg (文件) |  |
2 KB | Admin | 1 | |
| 2014年1月17日 (五) 11:51 | Bkjwe.jpg (文件) |  |
5 KB | Admin | 1 | |
| 2014年1月17日 (五) 11:51 | Bk4pw.jpg (文件) |  |
83 KB | Admin | 1 | |
| 2014年1月17日 (五) 11:51 | Gt2vsnk2.jpg (文件) |  |
10 KB | Admin | 1 | |
| 2014年1月17日 (五) 11:51 | Bk5i9.jpg (文件) |  |
7 KB | Admin | 1 | |
| 2014年1月17日 (五) 11:51 | Bk9um.jpg (文件) |  |
14 KB | Admin | 1 | |
| 2014年1月17日 (五) 11:52 | Gmoi36xo.jpg (文件) | 8 KB | Admin | 1 | ||
| 2014年1月17日 (五) 11:52 | Bkann.jpg (文件) |  |
19 KB | Admin | 1 | |
| 2014年1月17日 (五) 11:52 | Bk1x2.jpg (文件) |  |
32 KB | Admin | 1 | |
| 2014年1月17日 (五) 11:52 | Gmipd8ul.jpg (文件) |  |
12 KB | Admin | 1 | |
| 2014年1月17日 (五) 11:52 | Bk3sv.jpg (文件) |  |
19 KB | Admin | 1 | |
| 2014年1月17日 (五) 11:52 | Bk9eb.jpg (文件) |  |
34 KB | Admin | 1 | |
| 2014年1月17日 (五) 11:52 | Bkjik.jpg (文件) |  |
7 KB | Admin | 1 | |
| 2014年1月17日 (五) 11:52 | Bk6j7.jpg (文件) |  |
28 KB | Admin | 1 | |
| 2014年1月17日 (五) 11:53 | Gunudiir.jpg (文件) |  |
38 KB | Admin | 1 | |
| 2014年1月17日 (五) 11:53 | Bk0um.jpg (文件) |  |
84 KB | Admin | 1 | |
| 2014年1月17日 (五) 11:53 | Bk8jq.jpg (文件) |  |
7 KB | Admin | 1 | |
| 2014年1月17日 (五) 11:53 | Bkl0v.jpg (文件) |  |
7 KB | Admin | 1 | |
| 2014年1月17日 (五) 11:53 | Bk7ht.jpg (文件) |  |
9 KB | Admin | 1 | |
| 2014年1月17日 (五) 11:53 | Go84x8e2.gif (文件) |  |
2 KB | Admin | 1 | |
| 2014年1月17日 (五) 11:53 | Bkq0r.jpg (文件) |  |
11 KB | Admin | 1 | |
| 2014年1月17日 (五) 11:53 | Bkgr3.jpg (文件) |  |
86 KB | Admin | 1 | |
| 2014年1月17日 (五) 11:53 | IV.jpg (文件) |  |
36 KB | Admin | 1 | |
| 2014年1月17日 (五) 11:54 | Goy19yls.jpg (文件) | 4 KB | Admin | 1 | ||
| 2014年1月17日 (五) 11:54 | Bkgtv.jpg (文件) |  |
117 KB | Admin | 1 | |
| 2014年1月17日 (五) 11:54 | Bkkj3.jpg (文件) |  |
73 KB | Admin | 1 | |
| 2014年1月17日 (五) 11:54 | Bk657.jpg (文件) |  |
5 KB | Admin | 1 | |
| 2014年1月17日 (五) 11:54 | Gm7biy7f.jpg (文件) |  |
27 KB | Admin | 1 | |
| 2014年1月17日 (五) 11:54 | Bk0kd.jpg (文件) |  |
4 KB | Admin | 1 | |
| 2014年1月17日 (五) 11:54 | Gl3r8z2s.jpg (文件) |  |
15 KB | Admin | 1 |